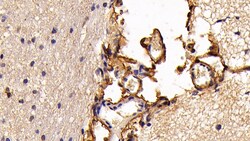
Invitrogen S100A10 Monoclonal Antibody (C3) 200 &mu;L; Unconjugated:Antibodies,

missing translation for 'onlineSavingsMsg'
Learn More
Learn More
Invitrogen™ S100A10 Monoclonal Antibody (C3)


Mouse Monoclonal Antibody
Supplier: Invitrogen™ MA566030
Description
S100A10 Monoclonal Antibody for Western Blot, ICC/IF, IHC (P)
The S-100 family of calcium-activated proteins interact with a range of target proteins to modulate biological signaling pathways. Numerous cancer cell lines overexpress the plasminogen receptor S-100A10 on the extracellular cell surface, where it forms a heterotetrameric complex with Annexin II, though this association is not required for plasma membrane localization or binding and activation of plasminogen. Additionally, S-100A10 acts as a cellular chaperone for hepatitis B (Hep B) virus polymerase. Hep B virus polymerase normally localizes to the cytoplasm only, though in the presence of S-100A10 a portion relocates to the nucleus, implying a role for S-100A10 and intracellular calcium in the process of viral replication.Chemical Identifiers
| S100A10 | |
| 1 mg/mL | |
| Immunohistochemistry (Paraffin), Western Blot, Immunocytochemistry | |
| Unconjugated | |
| Mouse | |
| RUO | |
| PBS with 50% glycerol and 0.05% ProClin 300; pH 7.4 | |
| P05943, P60903 | |
| 6281, 81778 | |
| Recombinant S100 Calcium Binding Protein A10 (S100A10) (Met1-Lys95). | |
| Antibody |
| C3 | |
| Store at 4°C short term. For long term storage, store at -20°C, avoiding freeze/thaw cycles. | |
| Monoclonal | |
| Liquid | |
| IgG1 κ | |
| Human, Rat | |
| S100A10 | |
| 42C; AA409961; AL024248; Annexin II; annexin II ligand; annexin II ligand, calpactin I, light polypeptide; annexin II tetramer (AIIt) p11 subunit; ANX2L; ANX2LG; Ca[1]; CAL12; Cal1l; calcium binding protein A11 (calgizzarin); calpactin I light chain; Calpactin-1 light chain; cellular ligand of annexin II; CLP11; GP11; MGC111133; MGC133268; Nerve growth factor-induced protein 42C; OTTHUMP00000015270; P PRSS26; p10; p10 protein; P11; p11 subunit; Protein S100 A10; Protein S100-A10; S100 calcium binding protein A10; S100 calcium binding protein A10 (annexin II ligand, calpactin I, light polypeptide (p11)); S100 calcium binding protein A10 (calgizzarin); S100 calcium binding protein A10 (calpactin); S100 calcium-binding protein A10; S100 calcium-binding protein A10 (annexin II ligand, calpactin I, light polypeptide (p11)); S-100 related protein, clone 42C; S100a10 | |
| S100A10 | |
| Primary | |
| Protein A/G |
Specifications
| S100A10 | |
| Monoclonal | |
| 1 mg/mL | |
| PBS with 50% glycerol and 0.05% ProClin 300; pH 7.4 | |
| P05943, P60903 | |
| S100A10 | |
| Recombinant S100 Calcium Binding Protein A10 (S100A10) (Met1-Lys95). | |
| 200 μL | |
| Primary | |
| Human, Rat | |
| Antibody | |
| IgG1 κ |
| Immunohistochemistry (Paraffin), Western Blot, Immunocytochemistry | |
| C3 | |
| Unconjugated | |
| S100A10 | |
| 42C; AA409961; AL024248; Annexin II; annexin II ligand; annexin II ligand, calpactin I, light polypeptide; annexin II tetramer (AIIt) p11 subunit; ANX2L; ANX2LG; Ca[1]; CAL12; Cal1l; calcium binding protein A11 (calgizzarin); calpactin I light chain; Calpactin-1 light chain; cellular ligand of annexin II; CLP11; GP11; MGC111133; MGC133268; Nerve growth factor-induced protein 42C; OTTHUMP00000015270; P PRSS26; p10; p10 protein; P11; p11 subunit; Protein S100 A10; Protein S100-A10; S100 calcium binding protein A10; S100 calcium binding protein A10 (annexin II ligand, calpactin I, light polypeptide (p11)); S100 calcium binding protein A10 (calgizzarin); S100 calcium binding protein A10 (calpactin); S100 calcium-binding protein A10; S100 calcium-binding protein A10 (annexin II ligand, calpactin I, light polypeptide (p11)); S-100 related protein, clone 42C; S100a10 | |
| Mouse | |
| Protein A/G | |
| RUO | |
| 6281, 81778 | |
| Store at 4°C short term. For long term storage, store at -20°C, avoiding freeze/thaw cycles. | |
| Liquid |